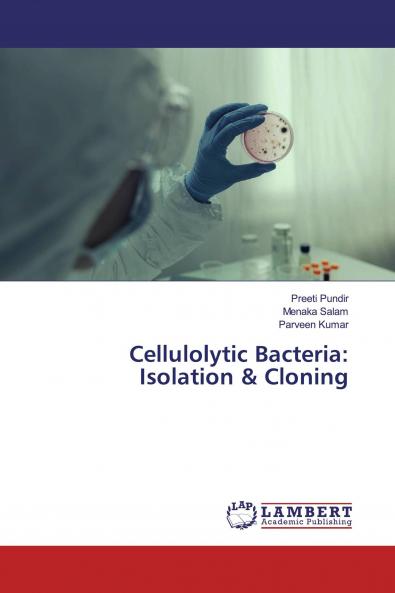
Cellulolytic Bacteria

English
Paperback
₹4195
(All inclusive*)
Delivery Options
Please enter pincode to check delivery time.
*COD & Shipping Charges may apply on certain items.
Review final details at checkout.
Looking to place a bulk order? SUBMIT DETAILS
About The Book
Description
Author
The use of cellulosic materials for second generation ethanol production would give several advantages such as minimizing the conflict between land use for food and fuel production providing less expensive raw materials than conventional agricultural feedstock allowing lower greenhouse gas emissions than those of first generation ethanol. However cellulosic biofuels are not produced at a competitive level yet mainly because of the high production costs of the cellulolytic enzymes. Therefore this study was aimed to identify new cellulolytic micro-organisms.
Delivery Options
Please enter pincode to check delivery time.
*COD & Shipping Charges may apply on certain items.
Review final details at checkout.
Details
ISBN 13
9786202563291
Publication Date
-09-06-2020
Pages
-68
Weight
-106 grams
Dimensions
-150x220x4.09 mm